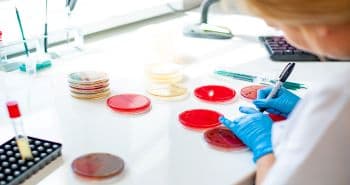
Ręka laboranta trzymająca probówki

Zapalenie języka. Objawy i leczenie
Podczas codziennej higieny jamy ustanej większość osób koncentruje się na dbałości o odpowiednie doczyszczenie zębów, dążąc do uzyskania efektu lśniąco białego uśmiechu. Często zapominamy o języku, który jest niezwykle istotnym wieloczynnościowym narządem odpowiedzialnym za odbieranie bodźców smakowych, rozdrabnianie pokarmów, połykanie i prawidłową artykulację mowy. Prawidłowy stan i czynność języka jest istotna w odpowiednim funkcjonowaniu organizmu. Jednak język, jak każdy z narządów naszego ciała mogą dotykać zmiany chorobowe; jednym z najczęściej występujących schorzeń jest zapalenie języka. Czym jest zapalenie języka? Jak rozpoznać tę chorobę i jakie leczenie należy stosować?

Czym jest zapalenie języka?
Zapalenie języka, czy też stan zapalny języka jest schorzeniem, w przebiegu którego dochodzi do obrzęku i stanu zapalnego języka. U pacjentów, u których rozwinęło się zapalenie języka, język staje się gładki i lekko błyszczący. Zapalenie języka może mieć charakter ostry, gdy zmiany chorobowe pojawiają się nagle lub przewlekły – w przypadku nawrotów choroby.
Do najczęściej występujących typów zapalenia języka zalicza się:
- Zanikowe zapalenie języka, nazywane również zapaleniem języka Huntera
W przebiegu choroby dochodzi do zaniku brodawek w efekcie czego język staje się gładki i błyszczący.
- Romboidalne zapalenie języka
W przebiegu choroby uwidaczniają się charakterystyczne owalne lub romboidalne niebolesne zmiany zlokalizowane w środkowej części grzbietowej (tj. górnej) powierzchni języka. Obszar zmieniony chorobowo jest wyraźnie odgraniczony, cechuje się atroficzną, gładką śluzówką pozbawioną brodawek nitkowatych.
- Język geograficzny, nazywany również rumieniem wędrującym języka
W przebiegu choroby dochodzi do zaniku brodawek nitkowatych na powierzchni języka.
Powstałe czerwonawe zmiany ograniczone są zazwyczaj wyniosłym białym brzegiem i przypominają układ znany z map, czemu choroba „zawdzięcza” swą nazwę. Zmiany te w trakcie trwania choroby mogą zmieniać kształt i lokalizację.
Zapalenie języka – objawy
Objawy zapalenia języka różnią się w zależności od przyczyny choroby i mogą wystąpić nagle lub rozwijać się dłuższy czas. Do typowych symptomów zgłaszanych przez pacjentów z zapaleniem języka należą: bolesność, zaczerwienienie i obrzęk języka. Mogą wystąpić także trudności w mówieniu, jedzeniu lub połykaniu, zaburzenia smaku. Na powierzchni języka często widoczny jest zanik brodawek.
Zapalenie języka – przyczyny
Zapalenie języka może mieć niezwykle zróżnicowaną etiologię. Wśród najważniejszych przyczyn można wymienić:
- Anemię, zarówno powodowaną niedoborem żelaza, jak i anemię złośliwą, tzw. chorobę Addisona-Biermera,
- Niedobór witamin z grupy B,
- Infekcje języka: wirusowe (np. w następstwie zakażenia wirusem opryszczki), grzybicze (najczęściej drożdżakami z rodzaju Candida); u osób z prawidłowo funkcjonującym układem odpornościowym zakażenia bakteryjne występują sporadycznie,
- Niektóre grupy leków takie jak: inhibitory konwertazy angiotensyny, salbutamol, leki przeciwdrobnoustrojowe zawierające siarkę (np. sulfatiazol), doustne środki antykoncepcyjne czy węglan litu,
- Podłoże psychogenne (np. w przebiegu zaburzeń lękowych i konwersyjnych),
- Łuszczycę i inne choroby autoimmunologiczne,
- Cukrzycę,
- Zespół piekących ust.
Istnieją przesłanki wskazujące, że łagodne migrujące zapalenie języka jest w pewnym stopniu dziedziczne. Poza wymienionymi przyczynami, zapalenie języka może być spowodowane przewlekłym narażeniem na czynniki drażniące, takie jak: duże ilości alkoholu, palenie papierosów czy częste spożywanie pikantnych potraw. Ryzyko zwiększają także częste urazy jamy ustnej, spowodowane np. źle dopasowaną protezą i oparzenia.
Dostępne są doniesienia opisujące przypadki romboidalnego zapalenia grzbietu języka spowodowanego intensywnym myciem języka szczoteczką do zębów. W takich przypadkach zaprzestanie intensywnego szczotkowania języka jest wystarczające do ustąpienia choroby.
Czy zapalenie języka jest zaraźliwe?
Samo zapalenie języka nie jest zaraźliwe. Niemniej jednak w przypadku infekcyjnej etiologii choroby, osoba nią dotknięta może przenosić infekcję na inne osoby. Dla przykładu, pacjent z zapaleniem języka spowodowanym wirusem opryszczki (HSV) jamy ustnej poprzez ślinę może zakazić wirusem osoby zdrowe.
Zapalenie języka – diagnostyka
Największe znaczenie w rozpoznaniu zapalenia języka ma badanie fizykalne. W trakcie badania lekarz dokonuje oceny wyglądu powierzchni języka (zarówno brzusznej jak i grzbietowej) oraz stanu błon śluzowych. Ocenie podlega również ogólny stan uzębienia, gdyż długotrwałe podrażniane języka przez ukruszone zęby może prowadzić do rozwoju zmian na błonie śluzowej. W zależności od wyników badania fizykalnego i podejrzewanej etiologii choroby, lekarz może zlecić dodatkowe badania takie jak:
- Wymaz i posiew bakteriologiczny z języka,
- Morfologia krwi,
- Oznaczenie żelaza w surowicy,
- Oznaczenie stężenia glukozy i hemoglobiny glikowanej,
- Badania biochemiczne,
- Oznaczenie stężenia witamin z grupy B (w przypadku podejrzenia niedoboru),
- Oznaczenia autoprzeciwciał (w przypadku podejrzenia chorób autoimmunologicznych).
Badania obrazowe nie są rutynowo wykonywane w diagnostyce zapalenia języka jednak w przypadku podejrzenia występowania zmian nowotworowych wykonuje się badanie rezonansu magnetycznego. W takich przypadkach lekarz może dodatkowo zdecydować o wykonaniu biopsji i skierowaniu materiału do badania histopatologicznego.
Zapalenie języka – leczenie i domowe sposoby
W leczeniu zapalenie języka istotne jest ustalenie przyczyny wystąpienia choroby. W przypadku infekcyjnego podłoża, lekarz wdroży odpowiednią farmakoterapię obejmującą antybiotyki, leki przeciwgrzybicze lub przeciwwirusowe, w zależności od czynnika infekcyjnego. U pacjentów dotkniętych awitaminozą lub z niedoborem żelaza zaleca się suplementację diety. W celu uśmierzenia bólu towarzyszącego zapaleniu języka zaleca się stosowanie płynów do higieny jamy ustnej zawierających w składzie substancje charakteryzują się działaniem przeciwzapalnym i przeciwobrzękowym, np. diklofenak i benzydaminę. Zapaleniu języka nie w każdym przypadku można skutecznie zapobiec. Niemniej jednak istnieją proste sposoby ograniczające ryzyko wystąpienia choroby takie jak:
stosowanie zdrowej diety, utrzymanie właściwej higieny jamy ustnej poprzez regularne szczotkowanie, nitkowanie i płukanie ust, unikanie substancji drażniących, takich jak papierosy oraz pikantne i kwaśne potrawy.
Autor: Dr n. o zdrowiu Piotr Choręza
Bibliografia:
- Median rhomboid glossitis caused by tongue-brushing. Shindo T. Cleve Clin J Med 2023; 90(1): 15-16. doi: 10.3949/ccjm.90a.21111.
- Glossitis. Sharabi AF, Winters R. StatPearls [Internet]. Treasure Island (FL): StatPearls Publishing, 2022.
- Prevalence and heritability of psoriasis and benign migratory glossitis in one Brazilian population. Jorge MA, Gonzaga HFS, Tomimori J, et al. An Bras Dermatol 2017; 92(6): 816-819. doi: 10.1590/abd1806-4841.20176389.
- Glossitis secondary to vitamin B12 deficiency anemia. Stoopler ET, Kuperstein AS. CMAJ 2013; 185(12): E582. doi: 10.1503/cmaj.120970.
- Zapalenia języka i inne wybrane jego zmiany o charakterze łagodnym. Mrówka-Kata K, Namysłowski G, Banert K, Ścierski W. Forum Medycyny Rodzinnej 2008; 2(2): 127–131.